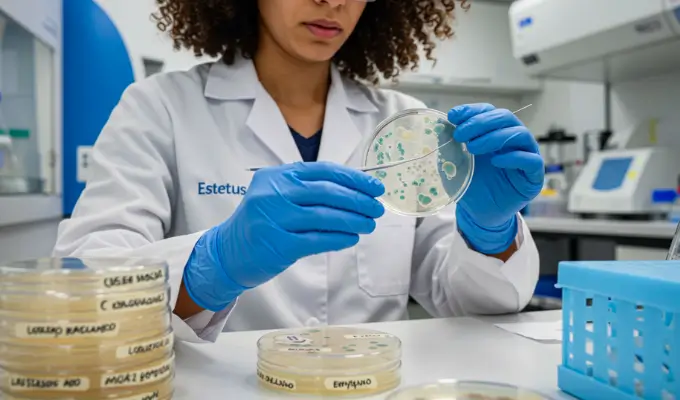

Cursos de Pós-Graduação
Conquiste reconhecimento, amplie suas possibilidades e destaque-se no mercado de trabalho. A Pós-Graduação oferece o conhecimento e as ferramentas que você precisa para alcançar o sucesso.
Se você busca cursos da área da saúde, clique aqui.